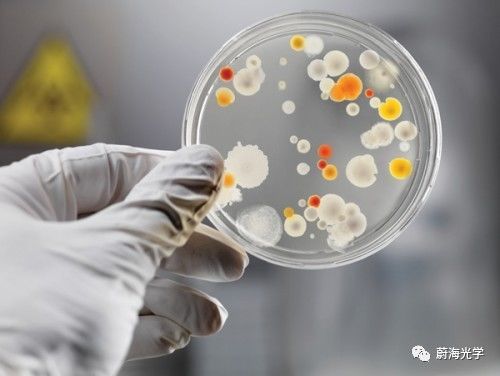

pixelteq,全球知名多光谱ag贵宾会的解决方案公司,于2017年9月,调整发展战略,正式回归海洋大家庭,成为海洋光学ag真人国际官网的旗下品牌。

发展历程
1999-2000年
ocean optics趁快速发展之即,收购了一家专门做光学元件的供应商,进而成立了自己的镀膜部门——ocean thin film,主要开发光谱镀膜、娱乐照明设备和军工光学产品。海洋创始人mike morris在一次偶然的机会,和当时的图案光谱镀膜的研发精英团队合作,共同开发了在半导体器件上进行光学镀膜的ag贵宾会的解决方案,简化了光学结构,降低了体积和成本,开发出了芯片级的光谱仪。
2008年
ocean thin film在成立短短数年之中获得巨大反响,为了能够拓展更大的市场空间,决定从海洋分离出来,和一个专注于多光谱传感和成像的团队合作,成立一家独立的公司,即pixelteq,共同归属英国豪迈集团。

这时候,镀膜技术已经从光学器件的表面镀膜,发展到对像素级的微区镀膜。在随后的几年里,pixelteq业务高速增长,不仅成为光学仪器的主要部件供应商,也成为了市场上最知名的舞台照明设备和美军主要的光学瞄准器件厂商之一。
2012年
pixelteq发布了一款多光谱相机,之后用仅仅一年的时间推出多光谱传感器,凭借不断开发的业务发展成为光传感领域中的佼佼者,应用范围覆盖了航空测绘,生物医学,远程传感,监管鉴伪,无人驾驶,水质监测等领域,比如宏观到对航天事业的深空探测、对文化遗产的鉴定鉴伪、以及对显微镜下微观世界的分析鉴别等。

2017年
在经历了近十年的奋斗后,为了能够更有效的利用先进镀膜技术,光谱和成像产品相结合,探寻更多更大的发展。pixelteq做出重要的战略决策——回归海洋光学大家庭,成为海洋子品牌。有了海洋光学和豪迈集团的支持合作,pixelteq剥离非核心业务,将焦点置于光谱行业。
主营产品

pixelsensor

紧凑型多通道光谱传感器
独特的芯片滤光技术,将8波段光电二极管集成到9*9cm的芯片上。可应用在体外诊断、生物化学实验和色度学等领域。

pixelcam

多光谱成像相机
同时实现3-9个光谱段的视频成像,无相差,无像素偏移。提供丰富的、实时的成像数据。可集成在手持设备、手机或者航空相机中,并且与单色相机在速度、分辨率、重量和功耗上完全兼容。

spectrocam

多通道光谱相机
同时在6-8个光谱段成像,不降低分辨率,速度可达25帧每秒,能够在数分钟内获得肉眼无法识别的实时图像。其多光谱成像系统可进行配置和定制化开发。
和传统光谱仪差别

主要优势
▶ 拥有世界最顶级的薄膜工程师和class 100洁净室,其宽镀膜平台技术包含了蒸发iad,磁控溅射和离子束溅射。
▶ 拥有着极高精度的光学滤波器技术,镀膜技术可实现像素大小。
▶ 微平板印刷工艺和精密对准技术,单个基底上的多层镀膜技术都广受市场好评。
